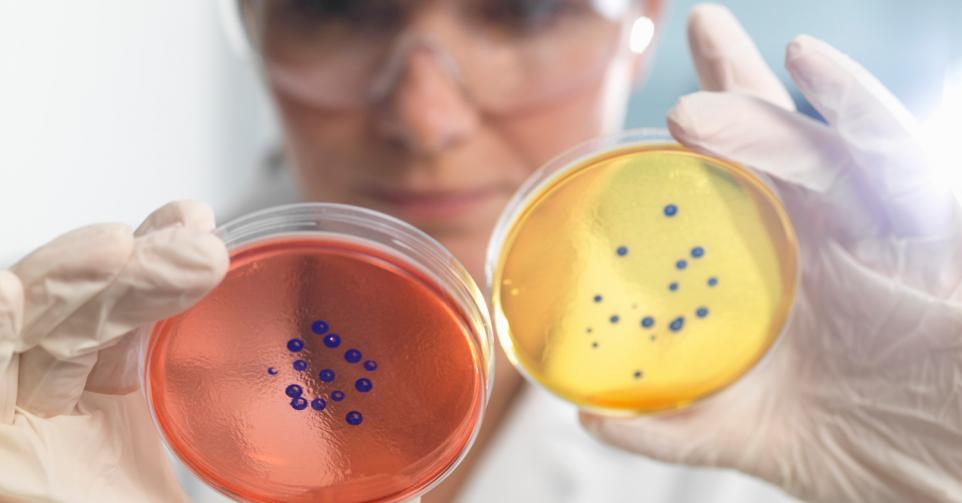

Comment prévenir la résistance aux antibiotiques
Dans un nouveau rapport international, des experts de la santé tirent la sonnette d’alarme face à la résistance croissante des bactéries aux antibiotiques. Plusieurs causes sont à l’origine de ce problème potentiellement mortel. Les chercheurs plaident dès lors pour des normes plus strictes encadrant l’usage des antibiotiques.
Les antibiotiques combattent les infections bactériennes, mais certaines bactéries survivent et deviennent insensibles au traitement. Elles se multiplient et transmettent cette résistance, rendant le médicament de moins en moins efficace avec le temps. Résultat : des infections aujourd’hui facilement traitables pourraient à l’avenir redevenir dangereuses, voire mortelles. Rien qu’en Europe, environ 25.000 personnes meurent chaque année des suites de la résistance aux antibiotiques; une menace silencieuse, mais croissante, pour la santé publique.
Les bactéries sont-elles si intelligentes?
Plusieurs facteurs expliquent cette adaptation des bactéries:
- Antibiotiques dans l’élevage: l’usage excessif d’antibiotiques chez les animaux a également un impact sur l’être humain, surtout lorsque les mêmes substances sont utilisées. Même dans les limites de la « Dose journalière admissible » (DJA), des bactéries résistantes peuvent apparaître.
- Mauvais diagnostic ou prescription inadaptée: les antibiotiques n’agissent que contre les bactéries, pas contre les virus responsables de maladies comme la grippe ou le rhume. Leur utilisation inutile favorise donc la résistance. Pourtant, en Belgique, environ 1000 traitements antibiotiques sont prescrits chaque année pour 1000 habitants – un chiffre nettement supérieur à celui d’autres pays européens.
- Mauvaise utilisation par le patient: la résistance se développe souvent après un usage répété ou prolongé du même antibiotique, ou lorsque les patients ne suivent pas correctement leur traitement (arrêt prématuré, non-respect des doses ou des horaires). Un usage imprudent rend de plus en plus de bactéries insensibles ; c’est pourquoi les antibiotiques ne doivent être utilisés que lorsqu’ils sont réellement nécessaires.
Lire aussi | Bien prendre ses médicaments
Qui est à risque?
Tout le monde peut être contaminé par des bactéries résistantes, qui se transmettent d’une personne à l’autre. Mais les individus à faible immunité, comme les patients hospitalisés ou les personnes de plus de 65 ans, sont les plus exposés : ils développent plus souvent des infections graves pour lesquelles les antibiotiques classiques ne fonctionnent plus.
En Belgique, quelque 103.000 patients hospitalisés chaque année (soit environ 7%) contractent une infection nosocomiale – c’est-à-dire une infection survenant pendant ou après un séjour ou un traitement dans un établissement de soins.
Peut-on inverser cette résistance?
Heureusement, il existe certaines mesures qui peuvent freiner la résistance et éventuellement la faire reculer.
- Thérapie par bactériophages: des chercheurs de l’Hôpital militaire Reine Astrid et de la KU Leuven travaillent sur la phagothérapie. Les bactériophages sont les ennemis naturels des bactéries, ils peuvent être utilisés pour cibler et détruire des bactéries nocives sans nuire aux bactéries bénéfiques. Cette approche prometteuse pourrait permettre de rendre certaines bactéries à nouveau sensibles aux antibiotiques.
- Utilisation correcte des antibiotiques: beaucoup de personnes ignorent que le respect strict du dosage et de la durée du traitement est essentiel. Quelques recommandations : prenez chaque jour la quantité prescrite, au moment indiqué, ne sautez jamais volontairement une prise, n’interrompez pas un traitement antibiotique de votre propre initiative – il est parfois possible de l’arrêter plus tôt, mais toujours en concertation avec votre médecin, n’utilisez jamais les restes d’un ancien traitement ni les antibiotiques d’autrui. Pour chaque infection, un médecin doit déterminer si un traitement antibiotique est nécessaire, lequel convient et quelle doit en être la durée. En cas de doute, vous pouvez consulter le site officiel du gouvernement consacré à l’usage des antibiotiques.
- Hygiène et désinfection: pour freiner la propagation des bactéries, l’hygiène des mains est primordiale : elles sont le principal vecteur de transmission. Lavez-vous donc régulièrement les mains à l’eau et au savon. Dans les hôpitaux, crèches, maisons de repos et autres institutions accueillant des personnes à risque, il est également recommandé d’utiliser une solution hydroalcoolique.
En conclusion
Pour ralentir la progression de la résistance aux antibiotiques, leur utilisation doit être considérablement réduite. C’est pourquoi le SPF Santé publique et le BAPCOC (Comité belge de coordination de la politique des antibiotiques) ont lancé une campagne de sensibilisation à l’usage approprié des antibiotiques. Leur objectif : faire passer le nombre de prescriptions de 1000 à 400 pour 1000 habitants d’ici 2025. Les médecins ne devraient prescrire des antibiotiques que lorsque le diagnostic le justifie réellement, et les patients doivent suivre leur traitement avec rigueur.
Vous avez repéré une erreur ou disposez de plus d’infos? Signalez-le ici